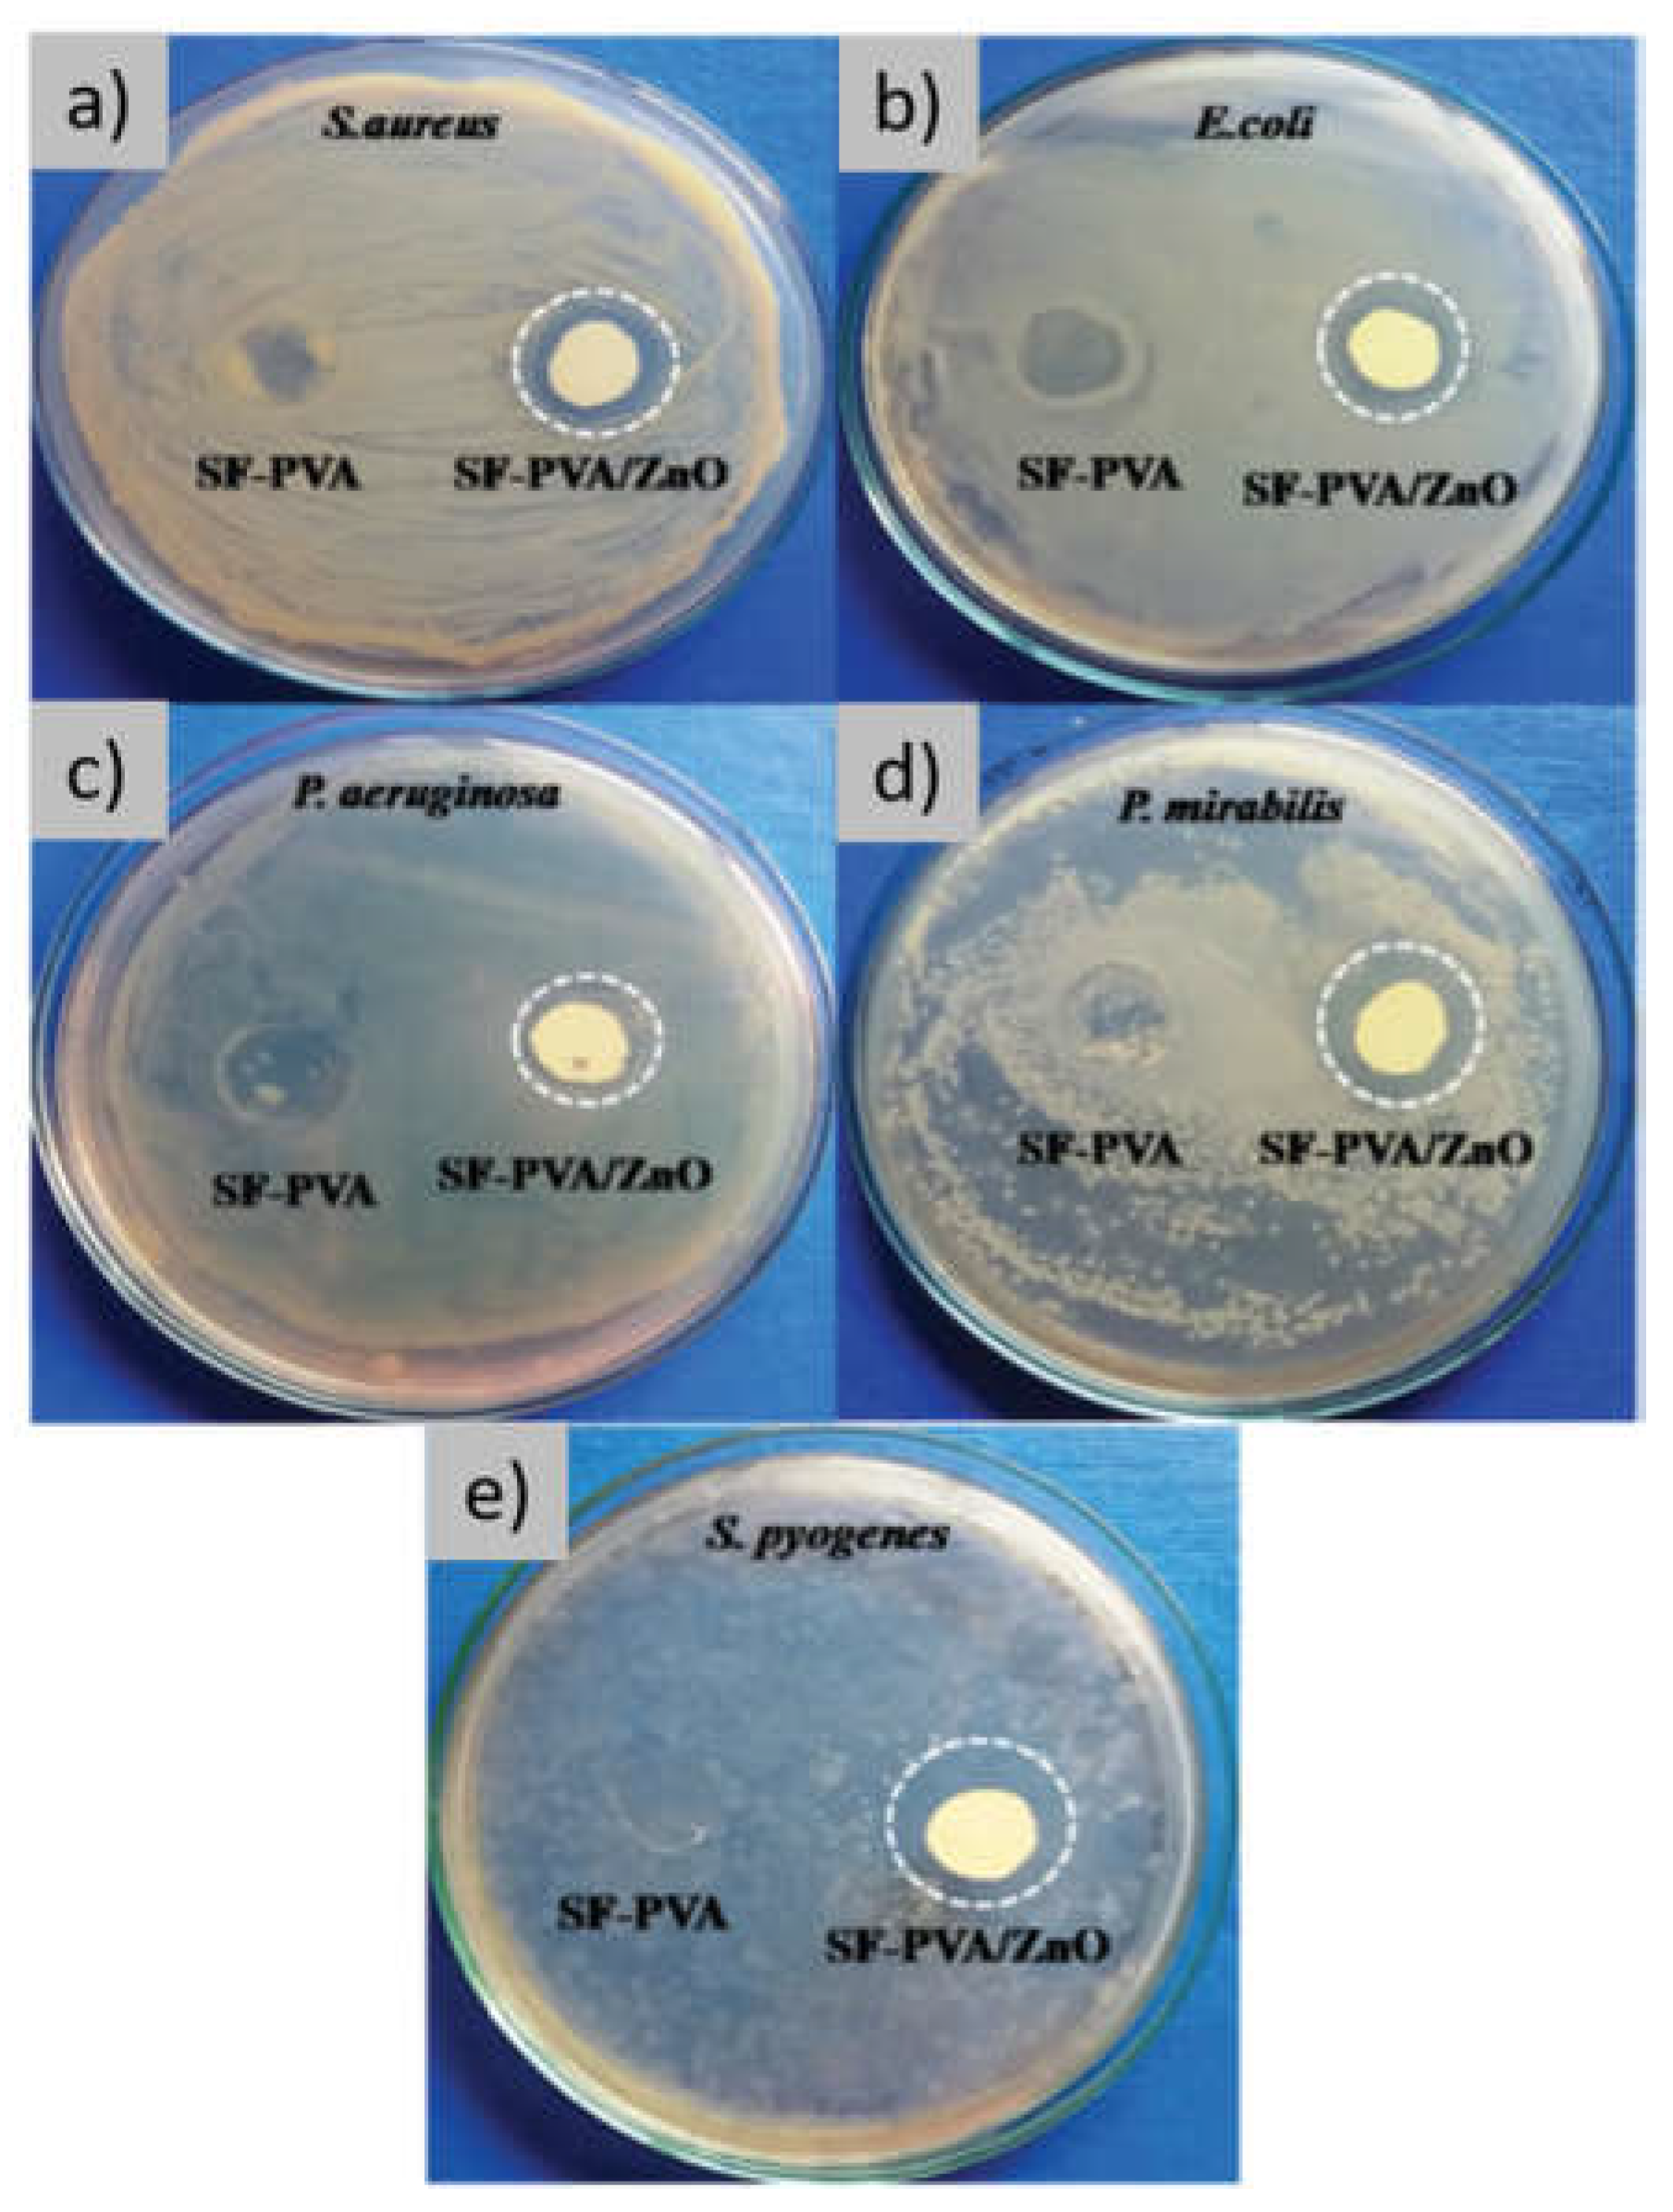
Preprints 141189 g002

Submitted:
28 November 2024
Posted:
29 November 2024
You are already at the latest version
Abstract
In recent years, several studies have focused their attention on the preparation of sustainable biocompatible and biodegradable films of potential interest in wound healing and wound dressing applications. In this regard, natural macromolecules—such as proteins—represent an attractive alternative to synthetic polymers thanks to their numerous advantages, such as biocompatibility, biodegradability, and low immunogenicity. Among the most interesting proteins, keratin extracted from waste wool and fibroin extracted from Bombyx mori cocoons, possess all of the abovementioned features required for biomedical applications. In the present review, we therefore aim to give an overview of the keratin and fibroin based films designed for wound healing and wound dressing applications and devices.
Keywords:
1. Introduction
2. Methods for Films Preparation
2.1. Solvent Casting
2.2. Salt Leaching
2.3. Spin Coating
2.4. Microfluidic Spinning
| Methods | Advantages | Disadvantages |
|---|---|---|
| Solvent casting | Cost-effectiveness Feasibility Suitable mechanical properties Good homogeneity |
Brittleness upon storage Difficult to scale up |
| Salt leaching | Easy and viable technique Tunable porosity and pore sizes |
Not for water-soluble materials Not complete removal of salts |
| Spin coating | Thickness control via spin speed Thickness uniformity |
Lack of material efficiency |
| Microfluidic spinning | Suitability for volatile compounds Reproducibility Capability of producing patterns |
Costly technique Need to determine process parameters |
3. Fibroin and Keratin Films for Wound Healing and Wound Dressing Applications
3.1. Films with Antimicrobial Function
3.2. Films with Antioxidant Function
3.3. Films with Growth Factors
3.4. Films with Anti-Inflammatory
| Mechanism of action | REF | |
| Antibiotics | Antimicrobial activity | [40] |
| Metal and metal oxide nanoparticles /inorganic nanomaterials | Avoid bacterial adhesion and biofilm formation through ROS generation | [41,42,43,44,45,46,89,90,91] |
| Honey | Sterilization Foster endothelial growth | [47,48,49,50,51,52,92,93,94,95] |
| Chitosan | Antimicrobial and drug release agent | [8,53,54,96] |
| Phenolic compounds from plant extracts | Inhibit microbial proliferation | [55] |
| Antimicrobial peptides | Antibacterial Angiogenic |
[56,97] |
| Photodynamic therapy | Antimicrobial through ROS generation | [57] |
| Mechanism of action | REF | |
| Vitamin C (VC), epigallocatechin gallate (EGCG), and curcumin | Preservative Stabilizing |
[61] |
| Curcumin | PreservativeStabilizing ROS scavenging Enhancing cellular proliferation and differentiation |
[22,62,63,64,65,66,67,68,98] |
| Pomegranate extract | Drug release agent Reducing oxidative stress in cells |
[69] |
| Chromophore | UV absorption | [70] |
| Keratoses | Iron-binding ability | [73] |
| Mechanism of action | REF | |
| EGF | Increase keratinocyte proliferation and migration | [75] |
| IGF-1 | Activation of the IGF1R pathway | [76,99,100] |
| Transgenic technology | Silkworm cocoons genetically engineered to produce human growth factors | [77] |
| Keratin-based products | Enhancing keratinocyte migration and collagen production | [78] |
| Mechanism of action | REF | |
| Modulation of films’ surface topography | Inducing differential macrophage polarization | [79] |
| Cytokines IFN-γ and IL-4 | Modulating macrophage polarization | [80] |
| Neurotensin | Reducing the inflammatory status Promoting fibroblast migration |
[82,83] |
| ZnAl HTIc-DIK | COX-1 and COX-2 inhibition Antimicrobial activity |
[84,85,86,87] |
| DIK | COX-1 and COX-2 inhibition Antimicrobial activity |
[88] |
4. Conclusions
Author Contributions
Funding
Institutional Review Board Statement
Informed Consent Statement
Data Availability Statement
Conflicts of Interest
References
- Borbolla-Jiménez, F. V.; Peña-Corona, S.I.; Farah, S.J.; Jiménez-Valdés, M.T.; Pineda-Pérez, E.; Romero-Montero, A.; Del Prado-Audelo, M.L.; Bernal-Chávez, S.A.; Magaña, J.J.; Leyva-Gómez, G. Films for Wound Healing Fabricated Using a Solvent Casting Technique. Pharmaceutics 2023, 15. [Google Scholar] [CrossRef] [PubMed]
- Sheokand, B.; Vats, M.; Kumar, A.; Srivastava, C.M.; Bahadur, I.; Pathak, S.R. Natural Polymers Used in the Dressing Materials for Wound Healing: Past, Present and Future. Journal of Polymer Science 2023, 61, 1389–1414. [Google Scholar] [CrossRef]
- Çalamak, S.; Erdoǧdu, C.; Özalp, M.; Ulubayram, K. Silk Fibroin Based Antibacterial Bionanotextiles as Wound Dressing Materials. Materials Science and Engineering C 2014, 43, 11–20. [Google Scholar] [CrossRef] [PubMed]
- Radulescu, D.M.; Andronescu, E.; Vasile, O.R.; Ficai, A.; Vasile, B.S. Silk Fibroin-Based Scaffolds for Wound Healing Applications with Metal Oxide Nanoparticles. J Drug Deliv Sci Technol 2024, 96. [Google Scholar] [CrossRef]
- Pollini, M.; Paladini, F. Bioinspired Materials for Wound Healing Application: The Potential of Silk Fibroin. Materials 2020, 13. [Google Scholar] [CrossRef]
- Lujerdean, C.; Baci, G.M.; Cucu, A.A.; Dezmirean, D.S. The Contribution of Silk Fibroin in Biomedical Engineering. Insects 2022, 13. [Google Scholar] [CrossRef]
- Gupta, B.; Agarwal, R.; Alam, M.S. Textile-Based Smart Wound Dressings; 2010; Vol. 35;
- Ganesan, P. Natural and Bio Polymer Curative Films for Wound Dressing Medical Applications. Wound Medicine 2017, 18, 33–40. [Google Scholar] [CrossRef]
- El-Sayed, H.; Taleb, M.A.; Mowafi, S. Potential Applications of Textile Wastes and By-Products in Preparation of Textile Auxiliaries. Egypt J Chem 2021, 64, 4433–4447. [Google Scholar]
- Rockwood, D.N.; Preda, R.C.; Yücel, T.; Wang, X.; Lovett, M.L.; Kaplan, D.L. Materials Fabrication from Bombyx Mori Silk Fibroin. Nat Protoc 2011, 6, 1612–1631. [Google Scholar] [CrossRef]
- Numata, K.; Kaplan, D.L. Silk-Based Delivery Systems of Bioactive Molecules. Adv Drug Deliv Rev 2010, 62, 1497–1508. [Google Scholar] [CrossRef]
- Sun, W.; Gregory, D.A.; Tomeh, M.A.; Zhao, X. Molecular Sciences Silk Fibroin as a Functional Biomaterial for Tissue Engineering. J. Mol. Sci 2021, 22, 1499. [Google Scholar] [CrossRef]
- Nguyen, T.P.; Nguyen, Q.V.; Nguyen, V.H.; Le, T.H.; Huynh, V.Q.N.; Vo, D.V.N.; Trinh, Q.T.; Kim, S.Y.; Van Le, Q. Silk Fibroin-Based Biomaterials for Biomedical Applications: A Review. Polymers (Basel) 2019, 11. [Google Scholar] [CrossRef] [PubMed]
- Vidya, M.; Rajagopal, S. Silk Fibroin: A Promising Tool for Wound Healing and Skin Regeneration. Int J Polym Sci 2021, 2021. [Google Scholar] [CrossRef]
- Chilakamarry, C.R.; Mahmood, S.; Saffe, S.N.B.M.; Arifin, M.A. Bin; Gupta, A.; Sikkandar, M.Y.; Begum, S.S.; Narasaiah, B. Extraction and Application of Keratin from Natural Resources: A Review. 3 Biotech 2021, 11. [Google Scholar] [CrossRef] [PubMed]
- Xu, H.; Cai, S.; Xu, L.; Yang, Y. Water-Stable Three-Dimensional Ultrafine Fibrous Scaffolds from Keratin for Cartilage Tissue Engineering. Langmuir 2014, 30, 8461–8470. [Google Scholar] [CrossRef]
- Giannelli, M.; Barbalinardo, M.; Riminucci, A.; Belvedere, K.; Boccalon, E.; Sotgiu, G.; Corticelli, F.; Ruani, G.; Zamboni, R.; Aluigi, A.; et al. Magnetic Keratin/Hydrotalcites Sponges as Potential Scaffolds for Tissue Regeneration. Appl Clay Sci 2021, 207. [Google Scholar] [CrossRef]
- Posati, T.; Ferroni, C.; Aluigi, A.; Guerrini, A.; Rossi, F.; Tatini, F.; Ratto, F.; Marras, E.; Gariboldi, M.B.; Sagnella, A.; et al. Mild and Effective Polymerization of Dopamine on Keratin Films for Innovative Photoactivable and Biocompatible Coated Materials. Macromol Mater Eng 2018, 303. [Google Scholar] [CrossRef]
- Aluigi, A.; Sotgiu, G.; Ferroni, C.; Duchi, S.; Lucarelli, E.; Martini, C.; Posati, T.; Guerrini, A.; Ballestri, M.; Corticelli, F.; et al. Chlorin E6 Keratin Nanoparticles for Photodynamic Anticancer Therapy. RSC Adv 2016, 6, 33910–33918. [Google Scholar] [CrossRef]
- dos Santos, F.V.; Siqueira, R.L.; de Morais Ramos, L.; Yoshioka, S.A.; Branciforti, M.C.; Correa, D.S. Silk Fibroin-Derived Electrospun Materials for Biomedical Applications: A Review. Int J Biol Macromol 2024, 254. [Google Scholar] [CrossRef]
- Savencu, I.; Iurian, S.; Porfire, A.; Bogdan, C.; Tomuță, I. Review of Advances in Polymeric Wound Dressing Films. React Funct Polym 2021, 168. [Google Scholar] [CrossRef]
- Alven, S.; Nqoro, X.; Aderibigbe, B.A. Polymer-Based Materials Loaded with Curcumin for Wound Healing Applications. Polymers (Basel) 2020, 12, 1–25. [Google Scholar] [CrossRef] [PubMed]
- Hodge, J.G.; Zamierowski, D.S.; Robinson, J.L.; Mellott, A.J. Evaluating Polymeric Biomaterials to Improve next Generation Wound Dressing Design. Biomater Res 2022, 26. [Google Scholar] [CrossRef] [PubMed]
- Karki, S.; Kim, H.; Na, S.J.; Shin, D.; Jo, K.; Lee, J. Thin Films as an Emerging Platform for Drug Delivery. Asian J Pharm Sci 2016, 11, 559–574. [Google Scholar] [CrossRef]
- Hou, Q.; Grijpma, D.W.; Feijen, J. Porous Polymeric Structures for Tissue Engineering Prepared by a Coagulation, Compression Moulding and Salt Leaching Technique. Biomaterials 2003, 24, 1937–1947. [Google Scholar] [CrossRef]
- Draczynski, Z.; Kolesinska, B.; Latanska, I.; Sujka, W. Preparation Method of Porous Dressing Materials Based on Butyric-Acetic Chitin Co-Polyesters. Materials 2018, 11. [Google Scholar] [CrossRef]
- Aramwit, P.; Ratanavaraporn, J.; Ekgasit, S.; Tongsakul, D.; Bang, N. A Green Salt-Leaching Technique to Produce Sericin/PVA/Glycerin Scaffolds with Distinguished Characteristics for Wound-Dressing Applications. J Biomed Mater Res B Appl Biomater 2015, 103, 915–924. [Google Scholar] [CrossRef]
- Liu, J.; Huang, R.; Li, G.; Kaplan, D.L.; Zheng, Z.; Wang, X. Generation of Nano-Pores in Silk Fibroin Films Using Silk Nanoparticles for Full-Thickness Wound Healing. Biomacromolecules 2021, 22, 546–556. [Google Scholar] [CrossRef]
- Sahu, N.; Panigrahi, S. Fundamental Understanding and Modeling of Spin Coating Process : A Review; 2009; Vol. 83;
- Wasapinyokul, K.; Kaewpirom, S.; Boonsang, S.; Chuwongin, S. Highly-Transparent Multi-Layered Spin-Coated Silk Fibroin Film.; SPIE-Intl Soc Optical Eng, October 24 2017; p. 31.
- Cheng, J.; Jun, Y.; Qin, J.; Lee, S.H. Electrospinning versus Microfluidic Spinning of Functional Fibers for Biomedical Applications. Biomaterials 2017, 114, 121–143. [Google Scholar] [CrossRef]
- Zhang, X.; Chen, Z.; Bao, H.; Liang, J.; Xu, S.; Cheng, G.; Zhu, Y. Fabrication and Characterization of Silk Fibroin/Curcumin Sustained-Release Film. Materials 2019, 12. [Google Scholar] [CrossRef]
- Sagnella, A.; Pistone, A.; Bonetti, S.; Donnadio, A.; Saracino, E.; Nocchetti, M.; Dionigi, C.; Ruani, G.; Muccini, M.; Posati, T.; et al. Effect of Different Fabrication Methods on the Chemo-Physical Properties of Silk Fibroin Films and on Their Interaction with Neural Cells. RSC Adv 2016, 6, 9304–9314. [Google Scholar] [CrossRef]
- Brown, J.E.; Davidowski, S.K.; Xu, D.; Cebe, P.; Onofrei, D.; Holland, G.P.; Kaplan, D.L. Thermal and Structural Properties of Silk Biomaterials Plasticized by Glycerol. Biomacromolecules 2016, 17, 3911–3921. [Google Scholar] [CrossRef] [PubMed]
- Belda Marín, C.; Egles, C.; Humblot, V.; Lalatonne, Y.; Motte, L.; Landoulsi, J.; Guénin, E. Gold, Silver, and Iron Oxide Nanoparticle Incorporation into Silk Hydrogels for Biomedical Applications: Elaboration, Structure, and Properties. ACS Biomater Sci Eng 2021, 7, 2358–2371. [Google Scholar] [CrossRef] [PubMed]
- Ghalei, S.; Handa, H. A Review on Antibacterial Silk Fibroin-Based Biomaterials: Current State and Prospects. Mater Today Chem 2022, 23. [Google Scholar] [CrossRef]
- Konop, M.; Rybka, M.; Drapała, A. Keratin Biomaterials in Skin Wound Healing, an Old Player in Modern Medicine: A Mini Review. Pharmaceutics 2021, 13. [Google Scholar] [CrossRef]
- Khajavi, R.; Rahimi, M.K.; Abbasipour, M.; Brendjchi, A.H. Antibacterial Nanofibrous Scaffolds with Lowered Cytotoxicity Using Keratin Extracted from Quail Feathers. J Bioact Compat Polym 2016, 31, 60–71. [Google Scholar] [CrossRef]
- Goyal, S.; Dotter, M.; Diestelhorst, E.; Storck, J.L.; Ehrmann, A.; Mahltig, B. Extraction of Keratin from Wool and Its Use as Biopolymer in Film Formation and in Electrospinning for Composite Material Processing. J Eng Fiber Fabr 2022, 17. [Google Scholar] [CrossRef]
- Yerra, A.; Mamatha, D.M. Antibiotic-Based Silk Fibroin Films for Burn Wound Healing. Polym Adv Technol 2021, 32, 861–871. [Google Scholar] [CrossRef]
- Kushwaha, A.; Goswami, L.; Kim, B.S. Nanomaterial-Based Therapy for Wound Healing. Nanomaterials 2022, 12. [Google Scholar] [CrossRef]
- Dizaj, S.M.; Lotfipour, F.; Barzegar-Jalali, M.; Zarrintan, M.H.; Adibkia, K. Antimicrobial Activity of the Metals and Metal Oxide Nanoparticles. Materials Science and Engineering C 2014, 44, 278–284. [Google Scholar] [CrossRef]
- Patil, P.P.; Meshram, J. V.; Bohara, R.A.; Nanaware, S.G.; Pawar, S.H. ZnO Nanoparticle-Embedded Silk Fibroin-Polyvinyl Alcohol Composite Film: A Potential Dressing Material for Infected Wounds. New Journal of Chemistry 2018, 42, 14620–14629. [Google Scholar] [CrossRef]
- Patil, P.P.; Bohara, R.A.; Meshram, J. V.; Nanaware, S.G.; Pawar, S.H. Hybrid Chitosan-ZnO Nanoparticles Coated with a Sonochemical Technique on Silk Fibroin-PVA Composite Film: A Synergistic Antibacterial Activity. Int J Biol Macromol 2019, 122, 1305–1312. [Google Scholar] [CrossRef] [PubMed]
- Patil, S.; Singh, N. Antibacterial Silk Fibroin Scaffolds with Green Synthesized Silver Nanoparticles for Osteoblast Proliferation and Human Mesenchymal Stem Cell Differentiation. Colloids Surf B Biointerfaces 2019, 176, 150–155. [Google Scholar] [CrossRef]
- Zhu, G.; Sun, Z.; Hui, P.; Chen, W.; Jiang, X. Composite Film with Antibacterial Gold Nanoparticles and Silk Fibroin for Treating Multidrug-Resistant E. Coli-Infected Wounds. ACS Biomater Sci Eng 2021, 7, 1827–1835. [Google Scholar] [CrossRef]
- Almasaudi, S. The Antibacterial Activities of Honey. Saudi J Biol Sci 2021, 28, 2188–2196. [Google Scholar] [CrossRef]
- Bizerra, F.C.; Da Silva, P.I.; Hayashi, M.A.F. Exploring the Antibacterial Properties of Honey and Its Potential. Front Microbiol 2012, 3. [Google Scholar] [CrossRef]
- Minden-Birkenmaier, B.A.; Bowlin, G.L. Honey-Based Templates in Wound Healing and Tissue Engineering. Bioengineering 2018, 5. [Google Scholar] [CrossRef]
- Tashkandi, H. Honey in Wound Healing: An Updated Review. Open Life Sci 2021, 16, 1091–1100. [Google Scholar] [CrossRef]
- Rajput, M.; Bhandaru, N.; Barui, A.; Chaudhary, A.; Paul, R.R.; Mukherjee, R.; Chatterjee, J. Nano-Patterned Honey Incorporated Silk Fibroin Membranes for Improving Cellular Compatibility. RSC Adv 2014, 4, 44674–44688. [Google Scholar] [CrossRef]
- Nachiappan, S. Silk Based Scaffolds in Combination with Honey and RhEGF for Diabetic Wound Healing.
- Rosewald, M.; Hou, F.Y.S.; Mututuvari, T. m; Harkins, A.; Tran, C. d (Invited) Cellulose-Chitosan-Keratin Composite Materials: Synthesis, Immunological and Antibacterial Properties. ECS Trans 2014, 64, 499–505. [Google Scholar] [CrossRef]
- Tran, C.D.; Mututuvari, T.M. Cellulose, Chitosan, and Keratin Composite Materials. Controlled Drug Release. Langmuir 2015, 31, 1516–1526. [Google Scholar] [CrossRef]
- Antibacterial Properties of Silk Fibroin-Chitosan Blend Films Loaded with Plant Extract.
- Si, R.; Chen, W.; Chen, J.; Yang, Y.; Zhou, W.; Zhang, Q.; Chen, C.; Han, B. Green Chemistry Fabrication of Durable Antimicrobial Peptide-Immobilized Silk Fibroin Films for Accelerated Full-Thickness Wound Healing. Mater Today Chem 2023, 29. [Google Scholar] [CrossRef]
- Aluigi, A.; Sotgiu, G.; Torreggiani, A.; Guerrini, A.; Orlandi, V.T.; Corticelli, F.; Varchi, G. Methylene Blue Doped Films of Wool Keratin with Antimicrobial Photodynamic Activity. ACS Appl Mater Interfaces 2015, 7, 17416–17424. [Google Scholar] [CrossRef] [PubMed]
- Sanchez, M.C.; Lancel, S.; Boulanger, E.; Neviere, R. Targeting Oxidative Stress and Mitochondrial Dysfunction in the Treatment of Impaired Wound Healing: A Systematic Review. Antioxidants 2018, 7. [Google Scholar] [CrossRef] [PubMed]
- Dunnill, C.; Patton, T.; Brennan, J.; Barrett, J.; Dryden, M.; Cooke, J.; Leaper, D.; Georgopoulos, N.T. Reactive Oxygen Species (ROS) and Wound Healing: The Functional Role of ROS and Emerging ROS-Modulating Technologies for Augmentation of the Healing Process. Int Wound J 2017, 14, 89–96. [Google Scholar] [CrossRef]
- Fadilah, N.I.M.; Phang, S.J.; Kamaruzaman, N.; Salleh, A.; Zawani, M.; Sanyal, A.; Maarof, M.; Fauzi, M.B. Antioxidant Biomaterials in Cutaneous Wound Healing and Tissue Regeneration: A Critical Review. Antioxidants 2023, 12. [Google Scholar] [CrossRef]
- Luo, T.; Yang, L.; Wu, J.; Zheng, Z.; Li, G.; Wang, X.; Kaplan, D.L. Stabilization of Natural Antioxidants by Silk Biomaterials. ACS Appl Mater Interfaces 2016, 8, 13573–13582. [Google Scholar] [CrossRef]
- Mohanty, C.; Sahoo, S.K. Curcumin and Its Topical Formulations for Wound Healing Applications. Drug Discov Today 2017, 22, 1582–1592. [Google Scholar] [CrossRef]
- Liang, G.; Yang, S.; Zhou, H.; Shao, L.; Huang, K.; Xiao, J.; Huang, Z.; Li, X. Synthesis, Crystal Structure and Anti-Inflammatory Properties of Curcumin Analogues. Eur J Med Chem 2009, 44, 915–919. [Google Scholar] [CrossRef]
- Ak, T.; Gülçin, I. Antioxidant and Radical Scavenging Properties of Curcumin. Chem Biol Interact 2008, 174, 27–37. [Google Scholar] [CrossRef]
- Mun, S.H.; Joung, D.K.; Kim, Y.S.; Kang, O.H.; Kim, S.B.; Seo, Y.S.; Kim, Y.C.; Lee, D.S.; Shin, D.W.; Kweon, K.T.; et al. Synergistic Antibacterial Effect of Curcumin against Methicillin-Resistant Staphylococcus Aureus. Phytomedicine 2013, 20, 714–718. [Google Scholar] [CrossRef]
- Joe, B.; Vijaykumar, M.; Lokesh, B.R. Biological Properties of Curcumin-Cellular and Molecular Mechanisms of Action. Crit Rev Food Sci Nutr 2004, 44, 97–111. [Google Scholar] [CrossRef] [PubMed]
- Akbik, D.; Ghadiri, M.; Chrzanowski, W.; Rohanizadeh, R. Curcumin as a Wound Healing Agent. Life Sci 2014, 116, 1–7. [Google Scholar] [CrossRef] [PubMed]
- Li, C.; Luo, T.; Zheng, Z.; Murphy, A.R.; Wang, X.; Kaplan, D.L. Curcumin-Functionalized Silk Materials for Enhancing Adipogenic Differentiation of Bone Marrow-Derived Human Mesenchymal Stem Cells. Acta Biomater 2015, 11, 222–232. [Google Scholar] [CrossRef] [PubMed]
- Barbalinardo, M.; Giannelli, M.; Forcini, L.; Luppi, B.; Donnadio, A.; Navacchia, M.L.; Ruani, G.; Sotgiu, G.; Aluigi, A.; Zamboni, R.; et al. Eco-Sustainable Silk Fibroin/Pomegranate Peel Extract Film as an Innovative Green Material for Skin Repair. Int J Mol Sci 2022, 23. [Google Scholar] [CrossRef]
- Chen, B.; Xing, Y.; Yu, W.; Liu, H. Wool Keratin and Silk Sericin Composite Films Reinforced by Molecular Network Reconstruction. J Mater Sci 2018, 53, 5418–5428. [Google Scholar] [CrossRef]
- Wright, J.A.; Richards, T.; Srai, S.K.S. The Role of Iron in the Skin and Cutaneous Wound Healing. Front Pharmacol 2014, 5 JUL.
- Aroun, A.; Zhong, J.L.; Tyrrell, R.M.; Pourzand, C. Iron, Oxidative Stress and the Example of Solar Ultraviolet A Radiation. Photochemical and Photobiological Sciences 2012, 11, 118–134. [Google Scholar] [CrossRef]
- Anceschi, A.; Patrucco, A.; Bhavsar, P.; Zoccola, M.; Tessari, M.; Erbazzi, L.; Zamboni, P. Keratose Self-Cross-Linked Wound Dressing for Iron Sequestration in Chronic Wounds. ACS Omega 2023, 8, 30118–30128. [Google Scholar] [CrossRef]
- Zhang, Y.; Atala, A. Regenerative Medicine of the Bladder. In Principles of Regenerative Medicine; Elsevier, 2018; pp. 1263–1279 ISBN 9780128098806.
- Gil, E.S.; Panilaitis, B.; Bellas, E.; Kaplan, D.L. Functionalized Silk Biomaterials for Wound Healing. Adv Healthc Mater 2013, 2, 206–217. [Google Scholar] [CrossRef]
- Lin, M.J.; Lu, M.C.; Chang, H.Y. Sustained Release of Insulin-like Growth Factor-1 from Bombyx Mori L. Silk Fibroin Delivery for Diabetic Wound Therapy. Int J Mol Sci 2021, 22. [Google Scholar] [CrossRef]
- Wang, S.L.; Li, X.W.; Xu, W.; Yu, Q.Y.; Fang, S.M. Advances of Regenerated and Functionalized Silk Biomaterials and Application in Skin Wound Healing. Int J Biol Macromol 2024, 254. [Google Scholar] [CrossRef]
- Tang, L.; Sierra, J.O.; Kelly, R.; Kirsner, R.S.; Li, J. Wool-Derived Keratin Stimulates Human Keratinocyte Migration and Types IV and VII Collagen Expression. Exp Dermatol 2012, 21, 458–460. [Google Scholar] [CrossRef] [PubMed]
- Hu, D.; Li, T.; Bian, H.; Liu, H.; Wang, P.; Wang, Y.; Sun, J. Silk Films with Distinct Surface Topography Modulate Plasma Membrane Curvature to Polarize Macrophages. Mater Today Bio 2024, 28. [Google Scholar] [CrossRef] [PubMed]
- Reeves, A.R.D.; Spiller, K.L.; Freytes, D.O.; Vunjak-Novakovic, G.; Kaplan, D.L. Controlled Release of Cytokines Using Silk-Biomaterials for Macrophage Polarization. Biomaterials 2015, 73, 272–283. [Google Scholar] [CrossRef] [PubMed]
- Moura, L.I.F.; Dias, A.M.A.; Suesca, E.; Casadiegos, S.; Leal, E.C.; Fontanilla, M.R.; Carvalho, L.; de Sousa, H.C.; Carvalho, E. Neurotensin-Loaded Collagen Dressings Reduce Inflammation and Improve Wound Healing in Diabetic Mice. Biochim Biophys Acta Mol Basis Dis 2014, 1842, 32–43. [Google Scholar] [CrossRef]
- Da Silva, L.P.; Neves, B.M.; Moura, L.; Cruz, M.T.; Carvalho, E. Neurotensin Decreases the Proinflammatory Status of Human Skin Fibroblasts and Increases Epidermal Growth Factor Expression. Int J Inflam 2014, 2014. [Google Scholar] [CrossRef]
- Lemos, C.N.; Cubayachi, C.; Dias, K.; Mendonça, J.N.; Lopes, N.P.; Furtado, N.A.J.C.; Lopez, R.F.V. Iontophoresis-Stimulated Silk Fibroin Films as a Peptide Delivery System for Wound Healing. European Journal of Pharmaceutics and Biopharmaceutics 2018, 128, 147–155. [Google Scholar] [CrossRef]
- Posati, T.; Giuri, D.; Nocchetti, M.; Sagnella, A.; Gariboldi, M.; Ferroni, C.; Sotgiu, G.; Varchi, G.; Zamboni, R.; Aluigi, A. Keratin-Hydrotalcites Hybrid Films for Drug Delivery Applications. Eur Polym J 2018, 105, 177–185. [Google Scholar] [CrossRef]
- Goh, C.F.; Lane, M.E. Formulation of Diclofenac for Dermal Delivery. Int J Pharm 2014, 473, 607–616. [Google Scholar] [CrossRef]
- Salem-Milani, A.; Balaei-Gajan, E.; Rahimi, S.; Moosavi, Z.; Abdollahi, A.; Zakeri-Milani, P.; Bolourian, M.; Salem Milani, A. Antibacterial Effect of Diclofenac Sodium on Enterococcus Faecalis; 2013; Vol. 10;
- Dutta, N.K.; Dastidar, S.G.; Asok Kumar,; Kaushiki Mazumdar,; Ray, R. ; Chakrabarty, A.N. ANTIMYCOBACTERIAL ACTIVITY OF THE ANTIINFLAMMATORY AGENT DICLOFENAC SODIUM, AND ITS SYNERGISM WITH STREPTOMYCIN. Brazilian Journal of Microbiology 2004, 35, 316–323. [Google Scholar] [CrossRef]
- Cui, L.; Gong, J.; Fan, X.; Wang, P.; Wang, Q.; Qiu, Y. Transglutaminase-Modified Wool Keratin Film and Its Potential Application in Tissue Engineering. Eng Life Sci 2013, 13, 149–155. [Google Scholar] [CrossRef]
- Paladini, F.; Pollini, M. Antimicrobial Silver Nanoparticles for Wound Healing Application: Progress and Future Trends. Materials 2019, 12. [Google Scholar] [CrossRef] [PubMed]
- Cadinoiu, A.N.; Rata, D.M.; Daraba, O.M.; Ichim, D.L.; Popescu, I.; Solcan, C.; Solcan, G. Silver Nanoparticles Biocomposite Films with Antimicrobial Activity: In Vitro and In Vivo Tests. Int J Mol Sci 2022, 23. [Google Scholar] [CrossRef] [PubMed]
- Panáček, A.; Kvítek, L.; Smékalová, M.; Večeřová, R.; Kolář, M.; Röderová, M.; Dyčka, F.; Šebela, M.; Prucek, R.; Tomanec, O.; et al. Bacterial Resistance to Silver Nanoparticles and How to Overcome It. Nat Nanotechnol 2018, 13, 65–71. [Google Scholar] [CrossRef] [PubMed]
- Mandal, M.D.; Mandal, S. Honey: Its Medicinal Property and Antibacterial Activity. Asian Pac J Trop Biomed 2011, 1, 154–160. [Google Scholar] [CrossRef] [PubMed]
- Scepankova, H.; Combarros-Fuertes, P.; Fresno, J.M.; Tornadijo, M.E.; Dias, M.S.; Pinto, C.A.; Saraiva, J.A.; Estevinho, L.M. Role of Honey in Advanced Wound Care. Molecules 2021, 26. [Google Scholar] [CrossRef]
- Ranzato, E.; Martinotti, S.; Burlando, B. Epithelial Mesenchymal Transition Traits in Honey-Driven Keratinocyte Wound Healing: Comparison among Different Honeys. Wound Repair and Regeneration 2012, 20, 778–785. [Google Scholar] [CrossRef]
- Yang, X.; Fan, L.; Ma, L.; Wang, Y.; Lin, S.; Yu, F.; Pan, X.; Luo, G.; Zhang, D.; Wang, H. Green Electrospun Manuka Honey/Silk Fibroin Fibrous Matrices as Potential Wound Dressing. Mater Des 2017, 119, 76–84. [Google Scholar] [CrossRef]
- Guang, S.; An, Y.; Ke, F.; Zhao, D.; Shen, Y.; Xu, H. Chitosan/Silk Fibroin Composite Scaffolds for Wound Dressing. J Appl Polym Sci 2015, 132. [Google Scholar] [CrossRef]
- Zhou, W.; Xie, Z.; Si, R.; Chen, Z.; Javeed, A.; Li, J.; Wu, Y.; Han, B. Actinomycin-X2-Immobilized Silk Fibroin Film with Enhanced Antimicrobial and Wound Healing Activities. Int J Mol Sci 2023, 24. [Google Scholar] [CrossRef]
- Mohanty, C.; Sahoo, S.K. Curcumin and Its Topical Formulations for Wound Healing Applications. Drug Discov Today 2017, 22, 1582–1592. [Google Scholar] [CrossRef]
- Garoufalia, Z.; Papadopetraki, A.; Karatza, E.; Vardakostas, D.; Philippou, A.; Kouraklis, G.; Mantas, D. Insulin-like Growth Factor-I and Wound Healing, a Potential Answer to Non-Healing Wounds: A Systematic Review of the Literature and Future Perspectives. Biomed Rep 2021, 15. [Google Scholar] [CrossRef]
- Lin, M.J.; Lu, M.C.; Chan, Y.C.; Huang, Y.F.; Chang, H.Y. An Insulin-like Growth Factor-1 Conjugated Bombyx Mori Silk Fibroin Film for Diabeticwound Healing: Fabrication, Physicochemical Property Characterization, and Dosage Optimization in Vitro and in Vivo. Pharmaceutics 2021, 13. [Google Scholar] [CrossRef]

Disclaimer/Publisher’s Note: The statements, opinions and data contained in all publications are solely those of the individual author(s) and contributor(s) and not of MDPI and/or the editor(s). MDPI and/or the editor(s) disclaim responsibility for any injury to people or property resulting from any ideas, methods, instructions or products referred to in the content. |
© 2024 by the authors. Licensee MDPI, Basel, Switzerland. This article is an open access article distributed under the terms and conditions of the Creative Commons Attribution (CC BY) license (http://creativecommons.org/licenses/by/4.0/).
